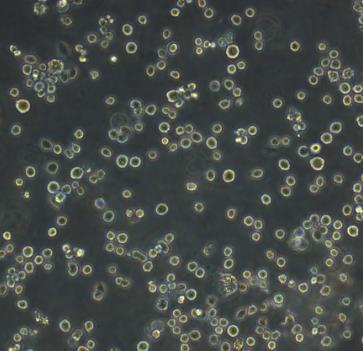

背景[1-3]
MUTZ-3急性非淋巴白血病悬浮细胞系是一种人类急性非淋巴白血病的细胞系,它是由一名患有急性髓系白血病的患者中分离出来的。这种细胞系在肿瘤学研究中具有重要价值,因为它可以用于评估新的治疗方法和药物的有效性,以及研究急性髓系白血病的发生和发展机制。
MUTZ-3急性非淋巴白血病悬浮细胞系通常被用于体外实验模型,例如细胞培养、基因转染、蛋白质表达等技术。研究人员可以通过改变培养条件、添加生长因子或使用基因编辑技术来改变MUTZ-3细胞系的行为,以更好地模拟体内环境并提高治疗效果。此外,MUTZ-3细胞系还可以用于研究肿瘤微环境对肿瘤生长和转移的影响。
MUTZ-3急性非淋巴白血病悬浮细胞系
MUTZ-3急性非淋巴白血病悬浮细胞系培养操作
1)复苏MUTZ-3急性非淋巴白血病悬浮细胞系:以下细胞培养冻存处理仅供参考,具体操作步骤以随货产品说明书为主。
将含有1mL细胞悬液的冻存管在37℃水浴中迅速摇晃解冻,加入4mL培养基混合均匀。在1000RPM条件下离心4分钟,弃去上清液,补加1-2mL培养基后吹匀。然后将所有细胞悬液加入培养瓶中培养过夜(或将细胞悬液加入10cm皿中,加入约8ml培养基,培养过夜)。第二天换液并检查细胞密度。
2)MUTZ-3急性非淋巴白血病悬浮细胞系传代:如果细胞密度达80%-90%,即可进行传代培养。
a、弃去培养上清,用不含钙、镁离子的PBS润洗细胞1-2次。
b、加1ml消化液(0.25%Trypsin-0.53mM EDTA)于培养瓶中,置于37℃培养箱中消化1-2分钟,然后在显微镜下观察细胞消化情况,若细胞大部分变圆并脱落,迅速拿回操作台,轻敲几下培养瓶后加少量培养基终止消化。
c、按6-8ml/瓶补加培养基,轻轻打匀后吸出,在1000RPM条件下离心4分钟,弃去上清液,补加1-2mL培养液后吹匀。
d、将细胞悬液按1:2比例分到新的含8ml培养基的新皿中或者瓶中。
3)MUTZ-3急性非淋巴白血病悬浮细胞系冻存:待细胞生长状态良好时,可进行细胞冻存。下面T25瓶为例;
a、收集细胞及细胞培养液,装入无菌离心管中,1000 rpm条件下离心4 min,弃去上清液,用PBS清洗一遍,弃尽PBS,进行细胞计数。
b、根据细胞数量加入无血清细胞冻存液,使细胞密度5×106~1×107/mL,轻轻混匀,每支冻存管冻存1mL细胞悬液,注意冻存管做好标识。
c、将冻存管放入-80℃冰箱,24 h后转入液氮灌储存。记录冻存管位置以便下次拿取。
应用[4-5]
MUTZ-3急性非淋巴白血病悬浮细胞系可以用于CLEC12A在急性髓系白血病中的表达特征、免疫调节作用及预后价值
急性髓系白血病(Acute myeloid leukemia,AML)是以髓系干/祖细胞异常自我增殖为特征的造血系统恶性肿瘤,是成人最常见的急性白血病类型。过去十几年间,AML发病率不断增加,但生存率并无明显改善。AML的治疗仍然依赖于联合化疗、自体或异体造血干细胞移植(HSCT)等。对于不适合强诱导化疗的AML老年患者,目前缺乏有效的治疗手段。
验证CLEC12A在AML LSCs中的表达特异性,探讨CLEC12A表达与AML临床病理特征和实验室指标的相关性及预后价值,进一步明确CLEC12A在AML中的潜在生物学功能病理机制,研究CLEC12A作为CAR-T细胞治疗靶点在AML中的作用,为AML的诊断、免疫治疗及预后提供理论依据。
研究方法1.验证CLEC12A在AML LSCs中的表达特异性:利用多种公共数据库和临床标本比较CLEC12A在各种类型肿瘤和细胞系中的表达差异,比较CLEC12A在正常HSCs和AML LSCs的表达差异,验证CLEC12A在AML LSCs中的表达特异性。
2. 分析CLEC12A表达与AML临床病理特征和实验室指标的相关性及预后价值:基于155名非M3初诊AML患者临床信息如年龄、性别、突变基因、细胞遗传学、分子生物学、实验室指标、随访期是否复发及随访期末是否生存等,分析CLEC12A表达与AML临床病理特征和实验室指标的相关性及生存分析。构建cox回归模型评估CLEC12A在AML患者中的独立预后价值。
3. 探讨CLEC12A在AML中的潜在生物学功能及病理机制:筛选CLEC12A高/低表达组差异表达基因,通过GO/KEGG富集分析及蛋白互作网络分析明确CLEC12A在AML中可能参与的生物学相关通路。
4. CLEC12A免疫相关分析:分析CLEC12A表达与10种免疫细胞浸润水平及免疫检查点基因的相关性,预测CLEC12A高/低表达组患者对ICB治疗的响应性差异。
研究结果1.CLEC12A在AML中表达显著上调。CLEC12A在AML样本及AML细胞系P31/FUJ、PL-21、AML-193和MUTZ-3急性非淋巴白血病悬浮细胞系中表达显著上调。CLEC12A在LSCs中显著高表达,而在正常造血干细胞不表达。
2. CLEC12A在AML中的预后价值。CLEC12A表达与WBC计数、FAB分类和细胞遗传学风险分层显著相关。CLEC12A低表达组IDH1,TP53,和TET2基因突变频率显著增高,但RUNX1基因突变频率显著降低。CLEC12A低表达提示预后不良。CLEC12A低表达是60岁以下并在缓解诱导期间接受强化治疗的非M3型AML患者的独立预后风险因素。
3. CLEC12A在AML中发挥重要的免疫调节作用。CLEC12A通过多种与免疫相关的通路参与AML多环节病理生理功能。CLEC12A高表达与M2巨噬细胞和单核细胞浸润呈正相关,与NK细胞和Tregs浸润呈负相关。CLEC12A高表达与CD47,HAVCR2,SIGLEC15,SIRPA和PDCD1LG2正相关,与PDCD1,TIGIT和LAG3呈负相关。CLEC12A高表达预示着对免疫检查点阻断治疗(ICB)疗效更好。
结论:在AML中,CLEC12A在LSCs中表达显著增高,可能是CAR-T细胞疗法的理想靶点。CLEC12A可作为AML一个新的预后生物标志物,补充目前AML预后风险分层系统,并发挥重要免疫调节作用。
参考文献
[1]Safety and efficacy of a humanized CD19 chimeric antigen receptor T Cells for relapsed/refractory acute lymphoblastic leukaemia..Shi Ming;Li Li;Wang Shiyuan;Cheng Hai;Chen Wei;Sang Wei;Qi Kunming;Li Zhenyu;Wang Gang;Li Huizhong;Lan Jianping;Huang Jinqi;Fei Xiaoming;Yu Min;Li Fei;Qiao Jianlin;Wu Qingyun;Zeng Lingyu;Jing Guangjun;Zheng Junnian;Gale Robert Peter;Xu Kailin;Cao Jiang.American journal of hematology,2022
[2]Neurotoxicity-associated sinus bradycardia after chimeric antigen receptor T-cell therapy..CataláEva;Iacoboni Gloria;VidalJordanaÁngela;Oristrell Gerard;Carpio Cecilia;Vilaseca Andreu;Cabirta Alba;Bosch Francesc;TintoréMar;Barba Pere.Hematological oncology,2022
[3]CAR-T Plus Radiotherapy:A Promising Combination for Immunosuppressive Tumors.Qin Vicky Mengfei;Haynes Nicole M.;D’Souza Criselle;Neeson Paul J.;Zhu Joe Jiang.Frontiers in Immunology,2022
[4]Strategies to overcome the side effects of chimeric antigen receptor T cell therapy..Mirzaee Godarzee Mohadeseh;Mahmud Hussen Bashdar;Razmara Ehsan;HakakZargar Benyamin;Mohajerani Fatemeh;Dabiri Hamed;Fatih Rasul Mohammed;Ghazimoradi Mohammad Hossein;Babashah Sadegh;Sadeghizadeh Majid.Annals of the New York Academy of Sciences,2022
[5]李俏俏.CLEC12A在急性髓系白血病中的表达特征、免疫调节作用及预后价值[D].郑州大学,2022.
